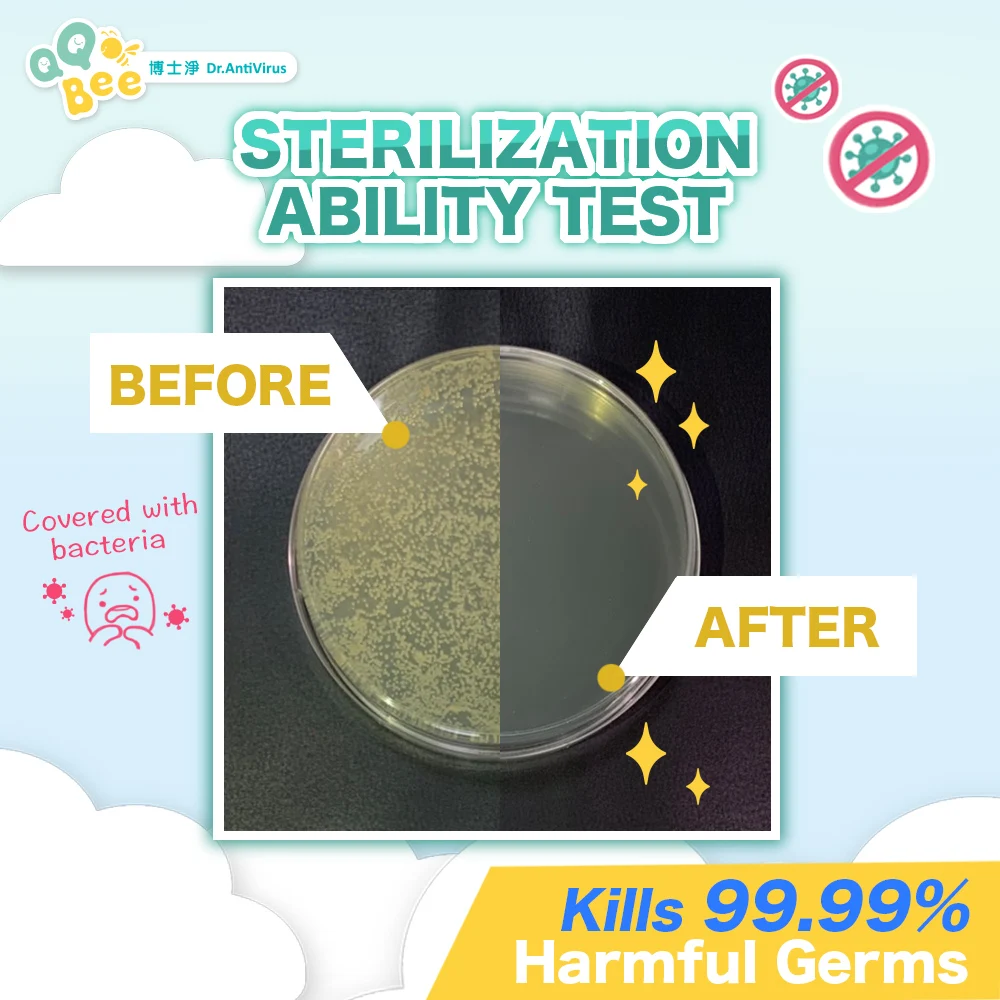
Exclusive Formula Sustainable Anti-bacterial Fragrance Free Refill Bottle Sanitizers Hand

Exclusive Formula Sustainable Anti bacterial Fragrance Free Refill Bottle Sanitizers Hand
- Category: >>>
- Supplier: Win-z technology co. ltd.
Share on (10000005845943):
Product Overview
Description
Products Show Room
Product Description

HS CODE | SIZE | PACKING (PER CARTON) | CARTON SIZE | BOTTLE TYPE |
3808940090 | 300ml/10.14 fl oz | 56 PCS | 36 CM*27 CM*42 CM | PP REFILL BOTTLE |
Certifications

Why Choose Us




Usage Proposal

OEM / ODM





Design Quality Control
Ingredients Quality Control
Appearance Inspection
Bacteriological Examination
PH Value Testing
OQC Per Shipment



FAQ
Q1 How do we know your products meets our require?
We provide samples for testing with the shipping cost covered by your side. All you need is to send us your inquiry.
Q2 What is your MOQ?
For RTS products. MOQ is 30 pcs per shipment.
For bulk goods (OEM/ODM). MOQ is 3000 pcs per shipment.
For bulk goods (OBM). MOQ is 10000 pcs per shipment.
Q3 What is your shipping terms?
EMS, FEDEX, DHL, TNT, UPS can be provided, also by sea and freight can be arranged.
Q4 What if my requirement is under MOQ?
Let us know. We will try to accommodate the quantity which you are okay with. As a long term cooperative partners. We know all the
business start with the least possible risks.
Q5 If I need a product which is not on your catalog. What can I do?
Just send us an inquiry and let us know your requirements. Our R&D team will provide you the products based on your need.
Q6 Why should I choose your products?
Focusing on ODM and OEM markets. We insist on providing safe, effective, and eco-friendly products. We follow the ISO 22716 and GMP to build the professional factory and establish advanced labs. Furthermore, all the products are produced and packed in the Class 10 clean rooms and under strict quality control by the QC department. With our professional R&D center and the exclusive formula, we can produce comprehensive products service from formula design all the way down to packaging design all depends on your special needs. As long as the products are from Winz, we pay attention to all the details and we promise you will get the best service.
We provide samples for testing with the shipping cost covered by your side. All you need is to send us your inquiry.
Q2 What is your MOQ?
For RTS products. MOQ is 30 pcs per shipment.
For bulk goods (OEM/ODM). MOQ is 3000 pcs per shipment.
For bulk goods (OBM). MOQ is 10000 pcs per shipment.
Q3 What is your shipping terms?
EMS, FEDEX, DHL, TNT, UPS can be provided, also by sea and freight can be arranged.
Q4 What if my requirement is under MOQ?
Let us know. We will try to accommodate the quantity which you are okay with. As a long term cooperative partners. We know all the
business start with the least possible risks.
Q5 If I need a product which is not on your catalog. What can I do?
Just send us an inquiry and let us know your requirements. Our R&D team will provide you the products based on your need.
Q6 Why should I choose your products?
Focusing on ODM and OEM markets. We insist on providing safe, effective, and eco-friendly products. We follow the ISO 22716 and GMP to build the professional factory and establish advanced labs. Furthermore, all the products are produced and packed in the Class 10 clean rooms and under strict quality control by the QC department. With our professional R&D center and the exclusive formula, we can produce comprehensive products service from formula design all the way down to packaging design all depends on your special needs. As long as the products are from Winz, we pay attention to all the details and we promise you will get the best service.
We Recommend
New Arrivals
New products from manufacturers at wholesale prices